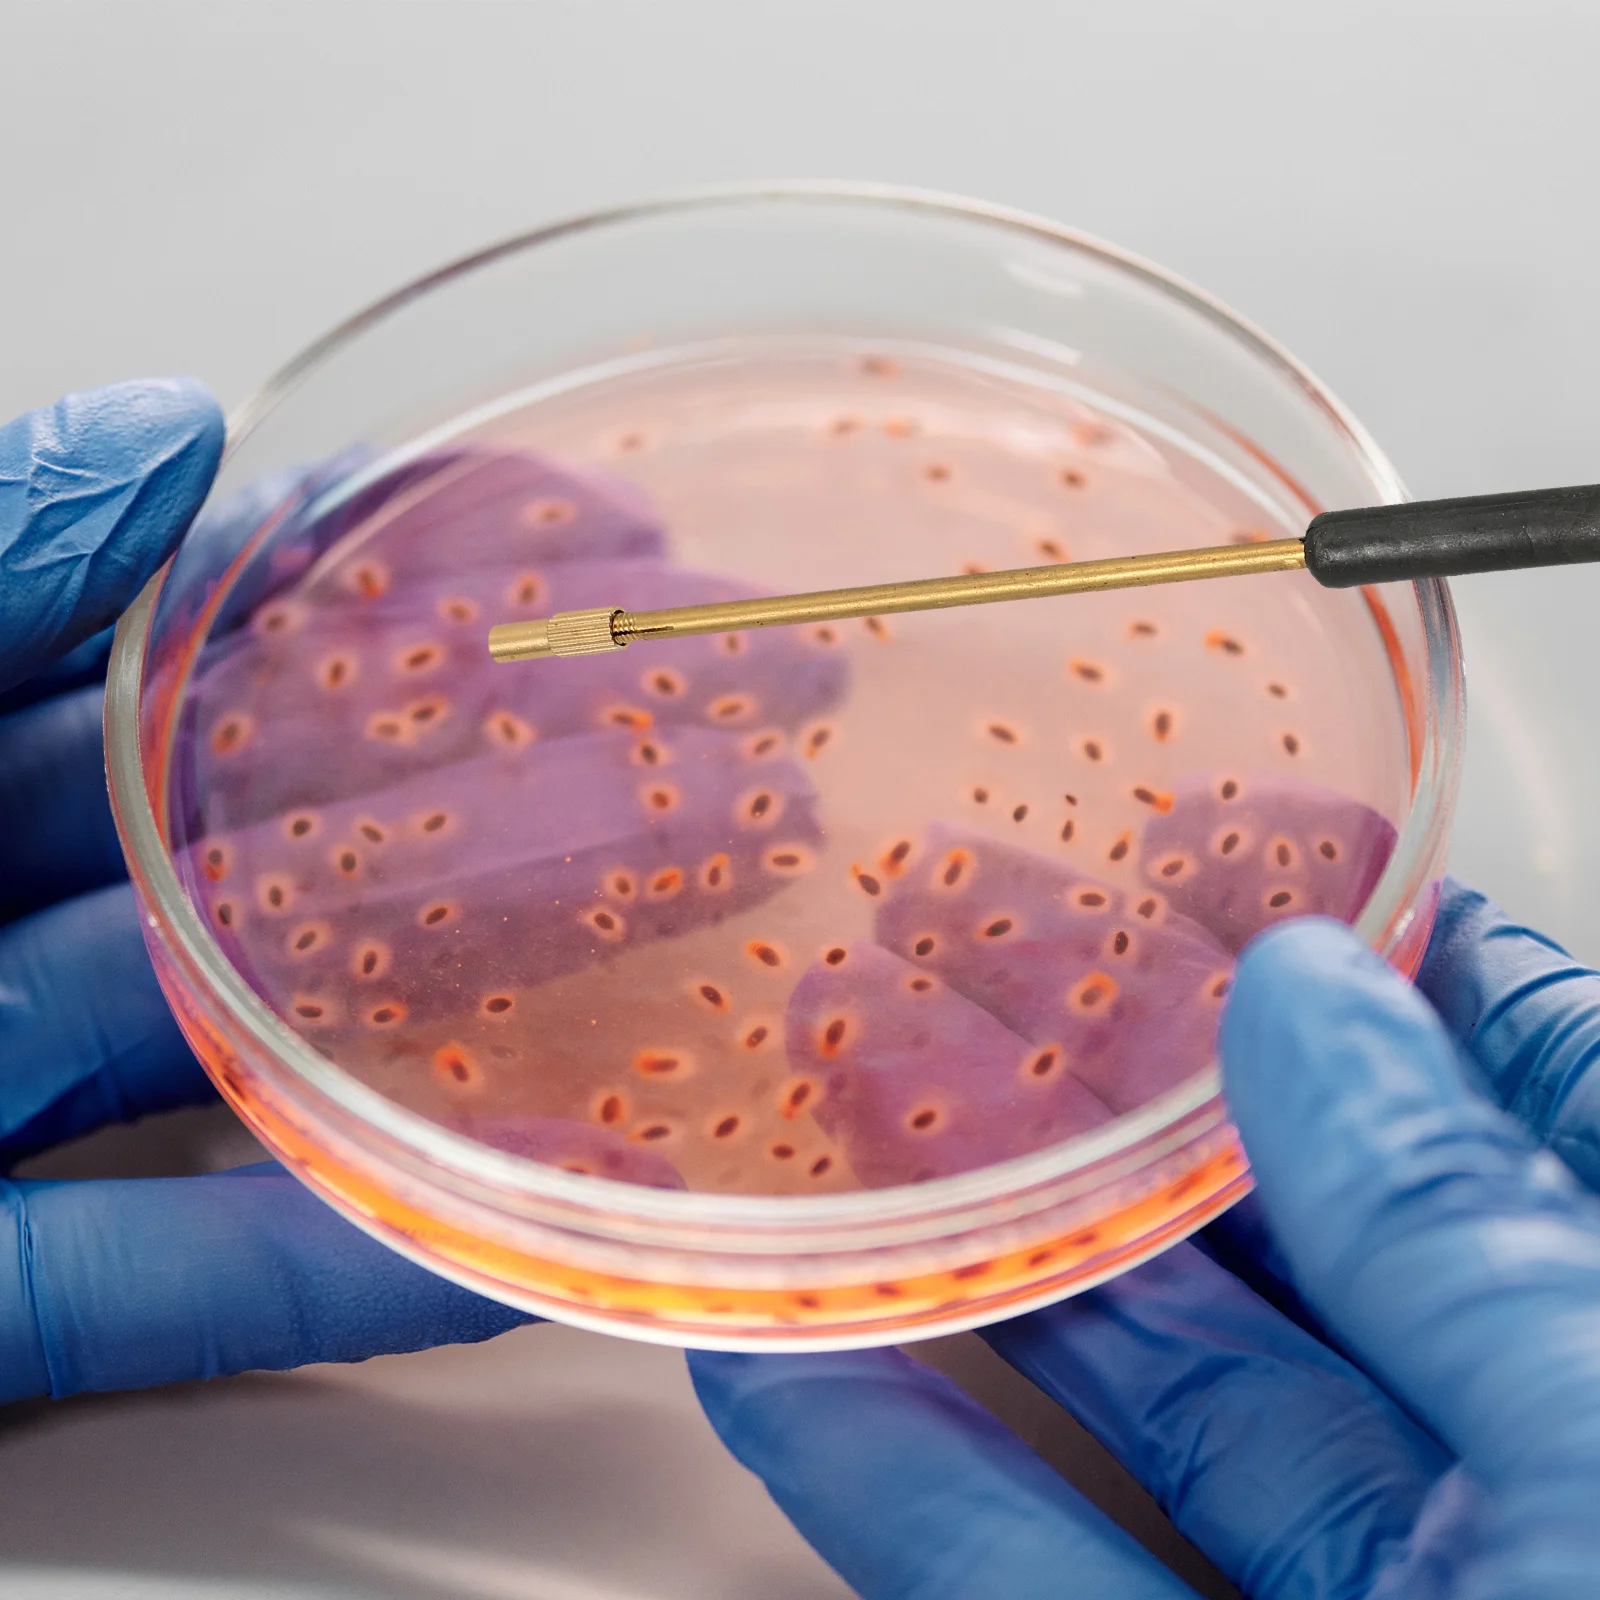
thumb

Pure Rod Inoculation Loop Laboratory Tool Supplies Microbiology Inoculating Stick
Price history chart & currency exchange rate
Customers also viewed

$47.67
Автозапчасти BBmart, 1 шт., левое крепление двигателя для Mercedes Benz ML550 GLS550 GL550 GL450 OE 1662405017 Оптовая цена
aliexpress.ru
$45.36
WISH 1.2G 1.3G VRX 8CH FPV видеоресивер PAL/NTSC 2-6S для Fatshark Skyzone FPV очки
aliexpress.ru
$94.90
ERIKC EJBR01801A EJBR01801Z Топливная форсунка 8200365186 Для Renault Clio Kangoo 1.5 Dci EJBR01801Z
aliexpress.ru
$33.68
Весенне-осенний стиль, китайское длинное стильное модифицированное платье Cheongsam 2025 года, новое облегающее платье Ципао с длинными рукавами в стиле ретро для молодых женщин
aliexpress.ru
$1,467.05
Чайный столик для гостиной из ясеня, большой градиентный гофрированный акриловый твердый деревянный чайный столик wabi-Sabi, Дизайнерские офисные столы и
aliexpress.ru
$420.21
Лидер продаж M3-M16 патрон консольная кнопка автоматический вертикальный универсальный нарезной станок 220 В/600 Вт электрический нарезной станок
aliexpress.ru
$5.92
2049052705 2045400517 2049053105 Датчик скорости колеса ABS для Mercedes Benz GLK320 GLK350 W204 X204 X164 204 905 27 05
aliexpress.ru
$7.42
Крючки для тяжелой атлетики, ремни для тяжелой атлетики, крючки для подъема, спортивные перчатки, 2X аксессуары для спортзала для мужчин, противоскользящие перчатки для тренировок
aliexpress.ru
$533.92
ZZR400 For KAWASAKI NINJA ZZR 400 112MC.139 ZZR-400 1993 1994 1995 1996 1997 1998 1999 00 01 02 03 05 06 07 black red Fairing
aliexpress.com
$35.10
Burmese Jade Lotus Pendant Chinese Natural Charms Necklace Jadeite Gift Fashion Emerald Green Jewelry Luxury Gemstone
aliexpress.com
$39.99
JOYO JF-16 British Sound Overdrive Guitar Effect Pedal Amplifier Simulator Get Tones Inspired By Marshall Amps True Bypass
aliexpress.com
$43.02
Зміцнювальний ліфтинговий крем для обличчя Bruno Vassari Lab Division Boosters Lifting & Firming Cream, 50 мл
eva.ua
$16.99
Женское Сетчатое нижнее белье, ажурная одежда, сексуальный экзотический боди, Сексуальное Кружевное боди с вырезами, прозрачное облегающее...
aliexpress.ru
$15.60
Футболка с вышивкой лисьей головы ADERERROR с принтом букв тяжелый ремесло с коротким рукавом
aliexpress.ru
$4.59
Accessories Windows Stainless Steel Home Door Chain Lock Door Bolts Thickened Buckle Thickened Door Inner Latch
aliexpress.ru
$7.10
Plate Plates Metal Tray Serving Steel Stainless Dish Dinnersalad Snack Dishes Fruit Appetizer Camping Cake Round Dessert Bowls
aliexpress.ru
$3.27
Pet Scarf Dog Christmascostumes Collar Cat Bell Dogs Hat Santa Neck Neckerchief Triangle Bandana Costume Cats Small Easter
aliexpress.ru
$3.25
Christmas Sticker Window Wall Stickers Decals Doorclings Glassdecal Decorations Decor Merry Removable Decoration Home Bauble
aliexpress.ru
$22.40
PANDOO модное очаровательное Оригинальное ювелирное изделие, зеленый милый детский кулон плюшевый мишка ожерелье женское роскошное ювелирно...
aliexpress.ru
$2.04
1 шт. Рождественское украшение сани микро пейзаж Снежная сцена кукольный домик миниатюрная Рождественская елка Снеговик Подарочная коробк...
aliexpress.ru
$96.69
Литиевая батарея для электромобиля Fiido D1 D2, 36 В, 10 Ач, 18650 упаковка 10S3P с 15A BMS 42 в для скутера 250 Вт, 350 Вт, 500 Вт
aliexpress.ru
$12.53
Воск для депиляции DEPILFLAX, Воск горячий пленочный в гранулах Азулен для чувствительной кожи
joybyjoy.ru
$19.68
Summer Lady Kimono Bath Robe Silky Satin Bride Bridesmaid Dressing Gown Casual Nightdress Nightwear Half Sleeve Home Wear, Black;red
dhgate.com
$9.35
6 Inch Ring Fill Light Dimmable Protable Led Photography Lighting 16cm Selfie For Youtube Live Streaming Photo Studio Video Lamp
aliexpress.com
$10.89
Сумка-рюкзак на одно плечо (кобура, слинг) Jeep Buluo Светло-коричневая J 604 LB
rozetka.com.ua
$16.16
men linen fashion short sleeve shirts baggy buttons summer solid comfortable pure cotton and linen casual loose shirts tee 1, White;black
dhgate.com
$30.06
black blue white shorts denim jeans summer denim shorts women hollow out bandage punk rock high waist, White;black
dhgate.com
$2.73
Шнурки для обуви без завязок, эластичные шнурки с ромбовидной пряжкой, кроссовки для детей и взрослых, подходят для спортивной повседневной обуви, ботинки
aliexpress.ru